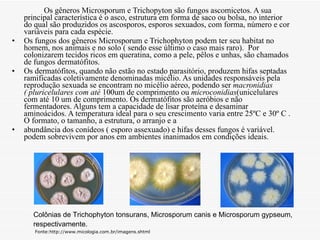
Os gêneros Microsporum e Trichopyton são fungos ascomicetos. A sua principal característica é o asco, estrutura em forma de saco ou bolsa, no interior do qual são produzidos os ascosporos, esporos sexuados, com forma, número e cor variáveis para cada espécie.  Os fungos dos gêneros Microsporum e Trichophyton podem ter seu habitat no homem, nos animais e no solo ( sendo esse último o caso mais raro).  Por colonizarem tecidos ricos em queratina, como a pele, pêlos e unhas, são chamados de fungos dermatófitos. Os dermatófitos, quando não estão no estado parasitório, produzem hifas septadas ramificadas coletivamente denominadas micélio. As unidades responsáveis pela reprodução sexuada se encontram no micélio aéreo, podendo ser  macronidias ( pluricelulares com até  100um de comprimento ou  microconidias (unicelulares com até 10 um de comprimento. Os dermatófitos são aeróbios e não fermentadores. Alguns tem a capacidade de lisar proteína e desaminar aminoácidos. A temperatura ideal para o seu crescimento varia entre 25ºC e 30º C . O formato, o tamanho, a estrutura, o arranjo e a abundância dos conídeos ( esporo assexuado) e hifas desses fungos é variável. podem sobrevivem por anos em ambientes inanimados em condições ideais. Colônias de Trichophyton tonsurans, Microsporum canis e Microsporum gypseum, respectivamente.   Fonte:http://www.micologia.com.br/imagens.shtml

O documento resume informações sobre várias doenças infecciosas, incluindo seus agentes causadores, sintomas, ciclos de vida e dados epidemiológicos. É descrito que a caxumba é causada por um vírus e transmitida por gotículas de saliva, a salmonelose por bactérias através de alimentos contaminados, e a pneumonia principalmente por bactérias transmitidas por ar ou sangue contaminados.
















![Ciclo de vida: [1] Ovos altamente contaminados que não eclodem [2] Ovos moderadamente contaminados que eclodem [4] mas os frangos não sobrevivem [3] Ovos bem pouco contaminados que eclodem [5] sobrevivem, crescem e continuam a excretar Samonella.](https://image.slidesharecdn.com/trabdebiologia-100531195846-phpapp02/85/Trab-de-biologia-17-320.jpg)